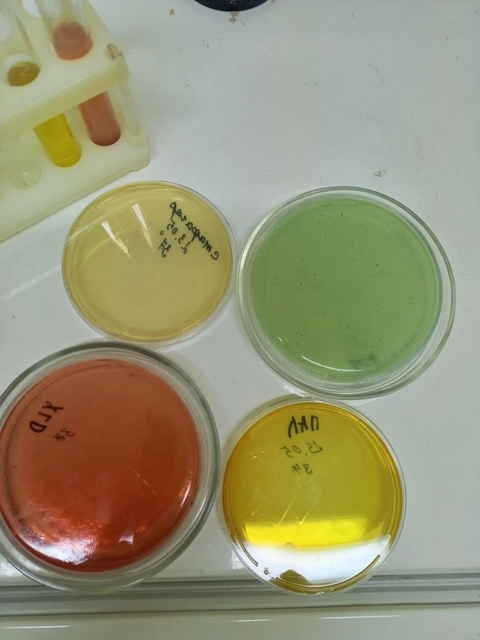

Сыр, древнейший продукт человеческой цивилизации, представляет собой не просто пищу, а целую культуру. Исследование сыра – это погружение в мир ароматов, текстур и вкусов, каждый из которых уникален и неповторим.
Начиная с истоков, сыр возник как способ сохранения молока в эпоху, когда холодильников не существовало. От простых, свежих сыров до выдержанных деликатесов, технология производства постоянно совершенствовалась, отражая географические особенности и кулинарные традиции различных народов.
Сегодня мир сыра огромен и разнообразен. От мягких бри и камамбера до твердых пармезана и гауды, каждый сорт обладает своими характеристиками. Процесс производства, от выбора молока до периода созревания, влияет на конечный продукт, даря ему исключительные качества.
Любители сыра ценят его за сложность вкуса, за возможность сочетать его с вином, фруктами и другими продуктами. Сыр – это не просто дополнение к столу, это самостоятельное блюдо, способное удивить и порадовать даже самых искушенных гурманов.
Микробиологические исследования сыра в лаборатории – это сложный и многоэтапный процесс, направленный на обеспечение безопасности и качества этого популярного продукта. Эти исследования охватывают широкий спектр задач, начиная от выявления патогенных микроорганизмов, способных вызвать заболевания, и заканчивая изучением полезных бактерий, формирующих уникальный вкус и аромат сыра.
В начале проводится отбор проб, который должен осуществляться в строгом соответствии с установленными стандартами, чтобы гарантировать репрезентативность образцов. Затем, в лабораторных условиях, применяются различные методы микробиологического анализа. К ним относятся классические методы, такие как посев на питательные среды для выявления и подсчета микроорганизмов, а также современные методы, такие как ПЦР (полимеразная цепная реакция), позволяющие быстро и точно идентифицировать определенные виды бактерий.
Особое внимание уделяется выявлению таких патогенов, как Salmonella, Listeria monocytogenes и Escherichia coli, которые могут представлять серьезную угрозу для здоровья потребителей. Кроме того, исследуется наличие плесеней и дрожжей, способных вызвать порчу продукта.
Важной частью исследований является изучение микрофлоры сыра, включая молочнокислые бактерии, которые играют ключевую роль в процессе ферментации и формировании органолептических свойств продукта. Анализ видового состава и активности этих бактерий позволяет контролировать процесс созревания сыра и оптимизировать его характеристики.
В заключение, результаты микробиологических исследований используются для оценки соответствия сыра установленным нормативам и стандартам безопасности, а также для разработки мер контроля качества на всех этапах производства.
Это обеспечивает выпуск безопасного и качественного продукта, отвечающего требованиям потребителей.